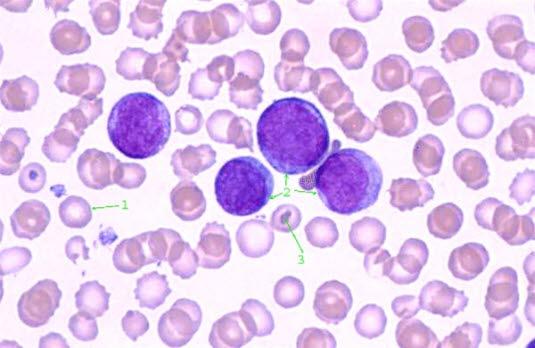
Hvite leukemiceller

Blod
Blodet består av to hoveddeler, blodceller og plasma - den væsken som blodcellene flyter rundt i. Blodcellene består av røde og hvite blodceller samt blodplater. Lymfesystemet er separat fra blodsystemet, men det tømmer seg i blodet.

Sist oppdatert:
11. jan. 2019
Fakta om blodet
- Røde og hvite
- Store og små
Røde blodceller

Hoveddelen av blodcellene utgjøres av de røde blodcellene. Deres viktigste oppgave er å frakte oksygen (surstoff) fra lungene til alle deler av kroppen. De røde blodcellene inneholder proteinet hemoglobin som binder til seg oksygen i lungene og som frigjør oksygenet til kroppens vev ettersom blodet sirkulerer rundt i kroppen. De røde blodcellene transporterer også en del av avfallsstoffet karbondioksyd fra vevene og til lungene slik at det kan pustes ut.
Hvite blodceller

Kroppen vår inneholder også flere typer hvite blodceller, som beskytter kroppen vår mot infeksjon. De fleste hvite blodcellene er såkalte myeloide celler, granulocytter, som angriper og fortærer bakterier. En annen type, lymfocytter, gjenkjenner fremmede celler, infeksiøse organismer og andre fremmede stoffer og deltar i kroppens immunreaksjon mot dem. Det finnes også andre typer hvite blodceller, men dette er to av de vanligste.
Blodplater

En tredje type blodceller er blodplater. Når et blodkar skades, samles blodplater som det første som skjer i en omfattende prosess (koagulasjonsprosessen) for å stanse blødningen. Kjemiske stoffer i plasma hjelper så blodplatene med å forme en blodpropp som tetter igjen hullet eller såret.
Lymfesystemet
De fleste røde blodcellene produseres i beinmargen. Det gjelder også granulocyttene - den største gruppen av hvite blodceller. Lymfocyttene produseres i hovedsak i lymfevevet utenfor beinmargen, som i lymfeknutene, milten, thymus, tonsillene og i mindre ansamlinger av lymfevev spredt rundt om i kroppen. Milten og lymfeknutene, sammen med lymfebaner og -kanaler som forbinder dem, kalles lymfesystemet. Når røde blodceller og blodplater blir gamle og fungerer dårligere, filtreres de ut av blodstrømmen og brytes ned i milten og leveren.
Sykdommer i blodet
Disse kan grupperes som følger:
- Mangel på hemoglobin fører til blodmangel, anemi
- Forstyrrelser i blodets evne til å levre seg, koagulere, fører til blødninger og blåmerker
- Kreftforandringer i de hvite cellene fører til leukemi eller sykdom i beinmargen
- Kreftforandringer i de hvite cellene kan også føre til forandringer i lymfesystemet med dannelse av lymfesvulster, lymfomer